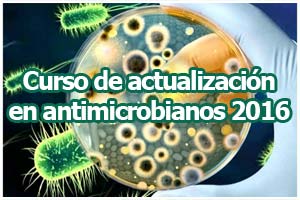
actualizacion-antimicrobianos-2016-destaque

ACTUALIZACIÓN EN ANTIMICROBIANOS 2016:
Curso Teórico – Práctico
Organizado por: Colegio de Bioquímicos de Tucumán
Dirección: Bioq. NORMA M. CUDMANI
Co-directora: Bioq. GABRIELA DELGADO
Responsables de prácticos: Bioq. Daniela Cudmani – Bioq. Guillermo González
OBJETIVOS
Brindar capacitación teórica y entrenamiento práctico a profesionales de la salud que se desempeñen en laboratorios de Bacteriología para establecer en la práctica diaria, los perfiles de sensibilidad a los antimicrobianos para su uso terapéutico.
DESTINATARIOS
Microbiólogos, médicos infectólogos y profesionales de carreras del área de la salud.
REQUISITOS DE ADMISIÓN PARA CURSO TEÓRICO-PRÁCTICO
Profesionales bioquímicos y otros profesionales de la salud.
Alumnos de la Facultad de Bioquímica con Bacteriología Clínica aprobada.
Cupo: 25 participantes.
OBJETIVO PRINCIPAL
Brindar capacitación teórica y entrenamiento práctico a los profesionales de la salud para establecer en la práctica diaria los perfiles de sensibilidad a los antimicrobianos para su uso terapéutico.
OBJETIVO ESPECÍFICOS
- Evaluar los mecanismos de resistencia y asesorar, en base a los informes que se generen en ellaboratorio, laantibioticoterapia más adecuada.
- Capacitar al profesional en su desempeño en la vigilancia de la resistencia bacteriana.
CONTENIDOS
Conceptos de sensibilidad y resistencia a los antimicrobianos. Pruebas de sensibilidad por diferentes metodologías. Actividad bactericida: su determinación en el laboratorio. Concepto de resistencia bacteriana. Sistemas de vigilancia de la resistencia.
Mecanismos de acción y resistencia a los antibióticos β- lactámicos. Uso clínico. Resistenciasde importancia clínica en Enterobacterias, bacilos Gram negativos no fermentadores, Staphylococcus spp, S. pneumoniae, H. influenzae, N. meningitidis y Streptococcus spp.
Glicopéptidos: mecanismo de acción y resistencias de impacto clínico en cocos Gram positivo. Uso clínico.
Mecanismos de acción y resistencia a otros antimicrobianos: aminoglucósidos, macrólidos, tetraciclinas, quinolonas, polipéptidos. Nuevos y viejos antimicrobianos. Métodos moleculares para detección de mecanismos de resistencia.
Farmacocinética y farmacodinamia.
Cultivos de vigilancia.
MODALIDAD
Cinco módulos presenciales con evaluación final.
Clases teóricas:
De 18.30 a 22.00 hs en Colegio de Bioquímicosde Tucumán. Av. República del Líbano 978.
- Módulo I – 27 y 28 de Junio.
- Módulo II – 25 y 26 de Julio.
- Módulo III – 22 y 23 de Agosto.
- Módulo IV – 19 y 20 de Setiembre.
- Módulo V – 24 y 25 de Octubre.
Clases prácticas:
De 14.00 a 17.30 hs. Laboratorio de Salud Pública. Mendoza 128. Piso 4.
- Módulo I – 28 de Junio.
- Módulo II – 26 de Julio.
- Módulo III – 23 de Agosto.
- Módulo IV – 20 de Setiembre.
- Módulo V – 25 de Octubre.
ARANCELES
Curso Teórico- Práctico:
- Profesionales: $800 por módulo o $3.600 curso completo en un solo pago.
- Bioquímicos socios del Colegio MP al día: $600 por módulo o $2.600 curso completo en un solo pago.
Curso Teórico:
- Bioquímicos socios del Colegio MP al día: $400 por módulo o $1.600 curso completo en un solo pago.
- Otros Profesionales de la Salud: $400 por módulo.
- Estudiantes y Técnicos: $300 por módulo o $1.100 curso completo en un solo pago.
Certificado de aprobación y/o asistencia:
- 80% de las clases teóricas y el 100% de las clases prácticas.
Fecha límite de inscripción para Teórico práctico hasta el 17 de Junio.
LAS INSCRIPCIONES DEBERÁ HACERSE EN EL COLEGIO DE BIOQUÍMICOS DE 8.00 A 12.00 HORAS. Av. República Del Líbano 978 – Tel. 4330805
PROGRAMA ANALÍTICO |
|
CRONOGRAMA |

Colegio de Bioquímicos de Tucumán
Colegio de Bioquímicos de Tucumán